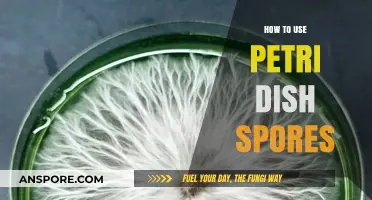
Mastering Petri Dish Spore Techniques for Successful Cultivation and Research

Epic Play Mod for Spore is a popular modification that enhances the gameplay experience by introducing new features, creatures, and mechanics to the original game. To use this mod, players first need to download and install it from a trusted source, ensuring compatibility with their version of Spore. Once installed, the mod unlocks a variety of customizable options, allowing players to create more complex and diverse creatures, explore expanded environments, and engage in new challenges. Users can access the mod’s features through the in-game interface, where they can experiment with advanced tools and settings to tailor their Spore experience. Whether you’re a seasoned player or new to the game, Epic Play Mod offers a fresh and immersive way to enjoy Spore’s unique evolution-based gameplay.
| Characteristics | Values |
|---|---|
| Mod Name | Epic Play Mod for Spore |
| Purpose | Enhances gameplay by adding new features, creatures, and customization options. |
| Compatibility | Works with Spore Galactic Adventures and other Spore expansions. |
| Installation | Requires downloading the mod files and placing them in the Spore Data folder. |
| Key Features | - New creatures and parts - Enhanced creature abilities - Expanded gameplay mechanics |
| Customization Options | Allows for more detailed creature designs and advanced editing tools. |
| Multiplayer Support | Limited; works best in single-player mode. |
| Performance Impact | May increase game load times due to additional content. |
| Updates | Regularly updated by the modding community. |
| Community Support | Active forums and Discord channels for troubleshooting and sharing creations. |
| System Requirements | Same as Spore base game, with additional storage for mod files. |
| Legal Status | Unofficial mod; use at own risk, as it may violate game terms of service. |
| Download Sources | Available on modding websites like Nexus Mods or Spore ModAPI. |
| Backup Recommendation | Back up Spore game files before installing the mod. |
| Known Issues | Occasional compatibility issues with other mods or game updates. |
| User Reviews | Highly rated for creativity and expanded gameplay possibilities. |
What You'll Learn
- Installation Guide: Download, extract files, and place in Spore’s Data folder to activate the mod
- Creature Editing: Unlock advanced parts, colors, and abilities for unique creature designs
- Building Tools: Create massive, detailed structures with expanded props and terrain options
- Gameplay Enhancements: Modify game speed, resources, and challenges for a customized experience
- Troubleshooting Tips: Fix crashes, compatibility issues, and common errors for smooth gameplay

Installation Guide: Download, extract files, and place in Spore’s Data folder to activate the mod
The first step in unleashing the potential of the Epic Play Mod for Spore is acquiring the mod files themselves. Navigate to a reputable modding website or forum, locate the Epic Play Mod download link, and initiate the download. Ensure you're downloading from a trusted source to avoid malware or corrupted files. Most mods are packaged in compressed archives like ZIP or RAR files, so be prepared to extract them after downloading.
Remember, downloading mods from unverified sources can pose security risks. Stick to well-known modding communities with active user feedback to minimize potential issues.
Once downloaded, locate the compressed mod file and extract its contents using a file archiver like WinRAR or 7-Zip. This process will create a new folder containing the mod's files, typically including a "Data" folder and possibly additional documentation or readme files. Pay close attention to the extracted folder structure, as it will mirror the organization required within Spore's Data folder for the mod to function correctly.
Some mods might require additional steps during extraction, such as entering passwords or selecting specific extraction options. Always refer to the mod's accompanying documentation or readme file for detailed instructions.
With the mod files extracted, it's time to integrate them into Spore's file structure. Navigate to your Spore installation directory, typically located in a folder like "Program Files (x86)/Electronic Arts/SPORE". Within this directory, locate the "Data" folder. This is where the mod's files need to be placed. Simply copy the contents of the extracted mod's "Data" folder and paste them into Spore's "Data" folder, overwriting any existing files if prompted.
This process essentially replaces or adds new data to Spore's core files, enabling the mod's functionality. Ensure you have a backup of your original Spore "Data" folder in case you need to revert to the unmodded version.
After placing the mod files in the correct location, launch Spore and verify the mod's activation. Depending on the mod's nature, you might notice immediate changes, such as new creatures, buildings, or gameplay mechanics. Some mods may require additional in-game configuration or activation through a mod menu. Refer to the mod's documentation or online resources for specific instructions on utilizing its features. Remember, modding can sometimes introduce unforeseen bugs or compatibility issues. If you encounter problems, double-check the mod's installation, ensure compatibility with your Spore version, and consult the modding community for troubleshooting assistance.
Fixing Weird Walking Spore: Simple Solutions for Healthy Plant Growth
You may want to see also

Creature Editing: Unlock advanced parts, colors, and abilities for unique creature designs
One of the most exciting aspects of the Epic Play Mod for Spore is its ability to transform creature editing from a constrained experience into a boundless creative playground. By unlocking advanced parts, colors, and abilities, players can craft creatures that defy the limitations of the base game. Imagine combining the sleek wings of a dragonfly with the robust body of a rhinoceros, all while tinting its skin in hues that shimmer like opals. This level of customization isn’t just about aesthetics; it’s about redefining what’s possible in your Spore universe.
To access these advanced features, start by enabling the Epic Play Mod in your game settings. Once activated, navigate to the creature editor and notice the expanded menus. Advanced parts, such as biomechanical limbs or ethereal appendages, are now available for selection. Experiment with layering these parts to create hybrid creatures that blend organic and inorganic elements seamlessly. For instance, a creature with metallic claws and translucent wings can become a centerpiece of your ecosystem. Remember, the mod allows for finer control over scaling and positioning, so take your time to adjust each part for maximum impact.
Color customization in the Epic Play Mod goes beyond the standard palette. Players can now apply gradients, glow effects, and even texture overlays to their creatures. To achieve a unique look, try using the color picker tool to sample hues from real-world images or artwork. For example, a creature inspired by a nebula could have a swirling blend of blues, purples, and pinks, enhanced with a subtle glow effect. Pair this with abilities like bioluminescence or camouflage to make your creature both visually stunning and functionally adaptive.
Abilities are another area where the Epic Play Mod shines. Unlike the base game, which restricts abilities based on creature stage, the mod allows players to mix and match abilities freely. A creature in the cell stage, for instance, could possess the ability to emit sonic waves or leave a trail of healing spores. This opens up new strategic possibilities, especially in the creature and tribal stages, where unique abilities can give your species a competitive edge. Experiment with combinations like flight, burrowing, and electricity to create a creature that dominates its environment.
While the Epic Play Mod offers unparalleled freedom, it’s important to balance creativity with practicality. Overloading a creature with too many advanced parts or abilities can make it unwieldy or disrupt the game’s balance. Start with a clear vision for your creature’s role in its ecosystem, whether it’s a predator, herbivore, or social species. Use the mod’s tools to enhance this role rather than overshadow it. For example, a predator might benefit from stealth abilities and sharp, advanced claws, while a social creature could have vibrant colors and communication-enhancing abilities. By focusing on purpose-driven design, you can create creatures that are not only visually striking but also meaningful additions to your Spore world.
Mastering Spore: Befriending the Grox with Smart Strategies and Tactics
You may want to see also

Building Tools: Create massive, detailed structures with expanded props and terrain options
The Epic Play Mod for Spore transforms the game’s building mechanics, allowing players to construct sprawling, intricate structures that defy the limitations of the base game. With expanded props and terrain options, creativity is no longer constrained by size or detail. Imagine designing a towering metropolis with skyscrapers that stretch into the clouds or a labyrinthine underground city carved into a mountain’s core—this mod makes it possible. The key lies in understanding how to leverage the new tools effectively, balancing ambition with practicality to avoid performance issues.
To begin, familiarize yourself with the mod’s interface, which adds new categories for props, terrain brushes, and structural elements. Start by experimenting with the terrain tools to shape the landscape to your vision. For instance, use the “Smooth” brush to create natural-looking hills or the “Raise” and “Lower” tools to carve out valleys and plateaus. Once the terrain is set, switch to the expanded prop library, which includes everything from tiny decorative items to massive architectural pieces. Combine these elements thoughtfully; a single oversized prop can serve as the centerpiece of a structure, while smaller items add depth and realism.
One of the most powerful features of the Epic Play Mod is its ability to handle massive structures without crashing the game. However, this doesn’t mean you should ignore performance considerations. Large-scale projects can still strain system resources, so work in stages. Build one section at a time, saving frequently and testing the game’s performance after each addition. If lag becomes an issue, reduce the complexity of less visible areas or use lower-poly props for distant objects. This iterative approach ensures your creation remains stable while pushing the boundaries of scale and detail.
For those aiming for hyper-detailed designs, the mod’s layering system is a game-changer. Place foundational elements first, such as walls and floors, then layer on decorative props and terrain details. For example, a castle can start with its stone walls and towers, followed by banners, torches, and even moss growing on the stones. This method not only enhances visual richness but also makes it easier to edit specific layers without disrupting the entire structure. Remember, the goal is to create a cohesive, immersive environment, so ensure each element complements the overall design.
Finally, don’t underestimate the importance of planning. Sketch out your ideas on paper or use a digital tool to map out the layout before diving into the game. This prevents mid-build redesigns, which can be time-consuming and frustrating. Consider the structure’s purpose within your Spore world—is it a bustling city, a sacred temple, or a hidden fortress? Tailor your design choices to tell a story, using the mod’s expanded tools to bring that narrative to life. With patience and creativity, the Epic Play Mod turns Spore’s building system into a sandbox for architectural masterpieces.
Histoplasmosis Spores Lifespan: How Long Do They Survive in Environments?
You may want to see also

Gameplay Enhancements: Modify game speed, resources, and challenges for a customized experience
Modifying game speed in Spore with the Epic Play Mod can dramatically alter your experience, from a leisurely exploration of evolution to a fast-paced race against time. The mod allows you to adjust the game’s internal clock, speeding up or slowing down progression through stages like Cell, Creature, Tribal, Civilization, and Space. For instance, setting the speed multiplier to 2.0 doubles the rate at which creatures evolve or civilizations expand, ideal for players who want to accelerate the early grind. Conversely, reducing the speed to 0.5 lets you savor intricate details, like crafting complex creatures or meticulously planning city layouts. Experiment with increments of 0.1 to find your preferred pace, balancing challenge with enjoyment.
Resource management is another critical aspect enhanced by the Epic Play Mod. By tweaking resource generation rates, you can tailor the game’s difficulty to your playstyle. For example, increasing spice or money production in the Civilization stage can simulate an economic boom, allowing you to focus on expansion and warfare. Alternatively, reducing resource availability introduces scarcity, forcing strategic decision-making and resource prioritization. A practical tip: set spice generation to 50% of the default value to create a survival-focused experience where every trade route and alliance matters. Pair this with increased disaster frequency for a truly unforgiving world.
Challenges in Spore become infinitely customizable with the mod’s ability to adjust enemy aggression, disaster frequency, and environmental hazards. In the Creature stage, ramping up predator aggression transforms the experience into a survival horror game, where every encounter is a fight for life. Similarly, in Space, increasing pirate activity or black hole frequency adds unpredictability and risk to interstellar travel. For a balanced approach, try setting predator aggression to 150% and disasters to occur twice as often, creating a dynamic world that demands adaptability. Just be cautious—overloading challenges can make the game frustrating rather than engaging.
Combining these enhancements allows for truly unique gameplay scenarios. Imagine a high-speed Space stage with abundant resources but frequent pirate attacks, encouraging rapid colonization and military buildup. Or a slow-paced Tribal stage with scarce food, forcing you to master hunting and foraging before advancing. The key is to experiment with combinations—start with small adjustments and gradually increase complexity as you become comfortable. For instance, pair a 1.5x game speed with 75% resource availability and moderate challenges for a fast-paced yet manageable experience. The Epic Play Mod’s flexibility ensures no two playthroughs feel the same, making Spore a sandbox of endless possibilities.
Adjusting Spore's Graphic Resolution: A Step-by-Step Guide for Gamers
You may want to see also

Troubleshooting Tips: Fix crashes, compatibility issues, and common errors for smooth gameplay
Modding *Spore* with the Epic Play Mod can breathe new life into the game, but it’s not without its challenges. Crashes, compatibility issues, and errors often arise, disrupting the immersive experience. Understanding the root causes is the first step to resolution. Common culprits include outdated game versions, conflicting mods, or insufficient system resources. Before diving into troubleshooting, ensure your *Spore* installation is updated to the latest version and that your system meets the mod’s requirements. This foundational check can save hours of frustration.
When crashes occur, start by isolating the issue. Disable all other mods and test the Epic Play Mod in a clean environment. If the game runs smoothly, reintroduce mods one by one to identify conflicts. Pay attention to error logs, which often provide clues about the problem. For instance, a "memory access violation" error suggests the mod is exceeding available RAM, requiring you to close background applications or upgrade your system. Additionally, verify the mod’s files for corruption by redownloading or reinstalling it.
Compatibility issues are another frequent hurdle, especially with older *Spore* versions or other popular mods. The Epic Play Mod is designed for specific game builds, so mismatches can lead to glitches or crashes. Cross-reference the mod’s compatibility list and ensure all components are aligned. If you’re using a mod manager, double-check its settings to avoid overwriting critical files. For persistent issues, consider reaching out to the modding community for tailored advice—forums and Discord groups are treasure troves of solutions.
Finally, addressing common errors requires a methodical approach. For example, the "failed to initialize graphics" error often stems from outdated graphics drivers or unsupported hardware. Update your GPU drivers and ensure your system meets the mod’s visual demands. Similarly, "script errors" typically indicate a problem with the mod’s code or installation path. Reinstall the mod, ensuring it’s placed in the correct directory, and run *Spore* as an administrator to bypass permission issues. By tackling these issues systematically, you’ll pave the way for uninterrupted, epic gameplay.
Heat's Role in Spore Staining: Enhancing Accuracy and Visualization
You may want to see also
Frequently asked questions
The Epic Play Mod for Spore is a comprehensive modification that overhauls the game's mechanics, adding new features, creatures, and challenges. It enhances the game by introducing more depth to the creature stage, tribe stage, and space stage, with improved AI, expanded tools, and a more immersive experience.
To install the Epic Play Mod, first ensure you have Spore and its expansions installed. Download the mod from a trusted source, extract the files, and place them in the Spore "Data" folder. Launch the game and activate the mod from the in-game mod menu or by selecting the appropriate save file.
The Epic Play Mod is designed to be compatible with many other Spore mods, but conflicts may arise depending on the specific mods used. It’s recommended to check the mod’s documentation or community forums for compatibility lists and troubleshooting tips.
Key features include enhanced creature customization, expanded tribal warfare mechanics, more complex space stage interactions, and new creatures and environments. The mod also introduces harder difficulties and improved AI behavior for a more challenging and engaging gameplay experience.